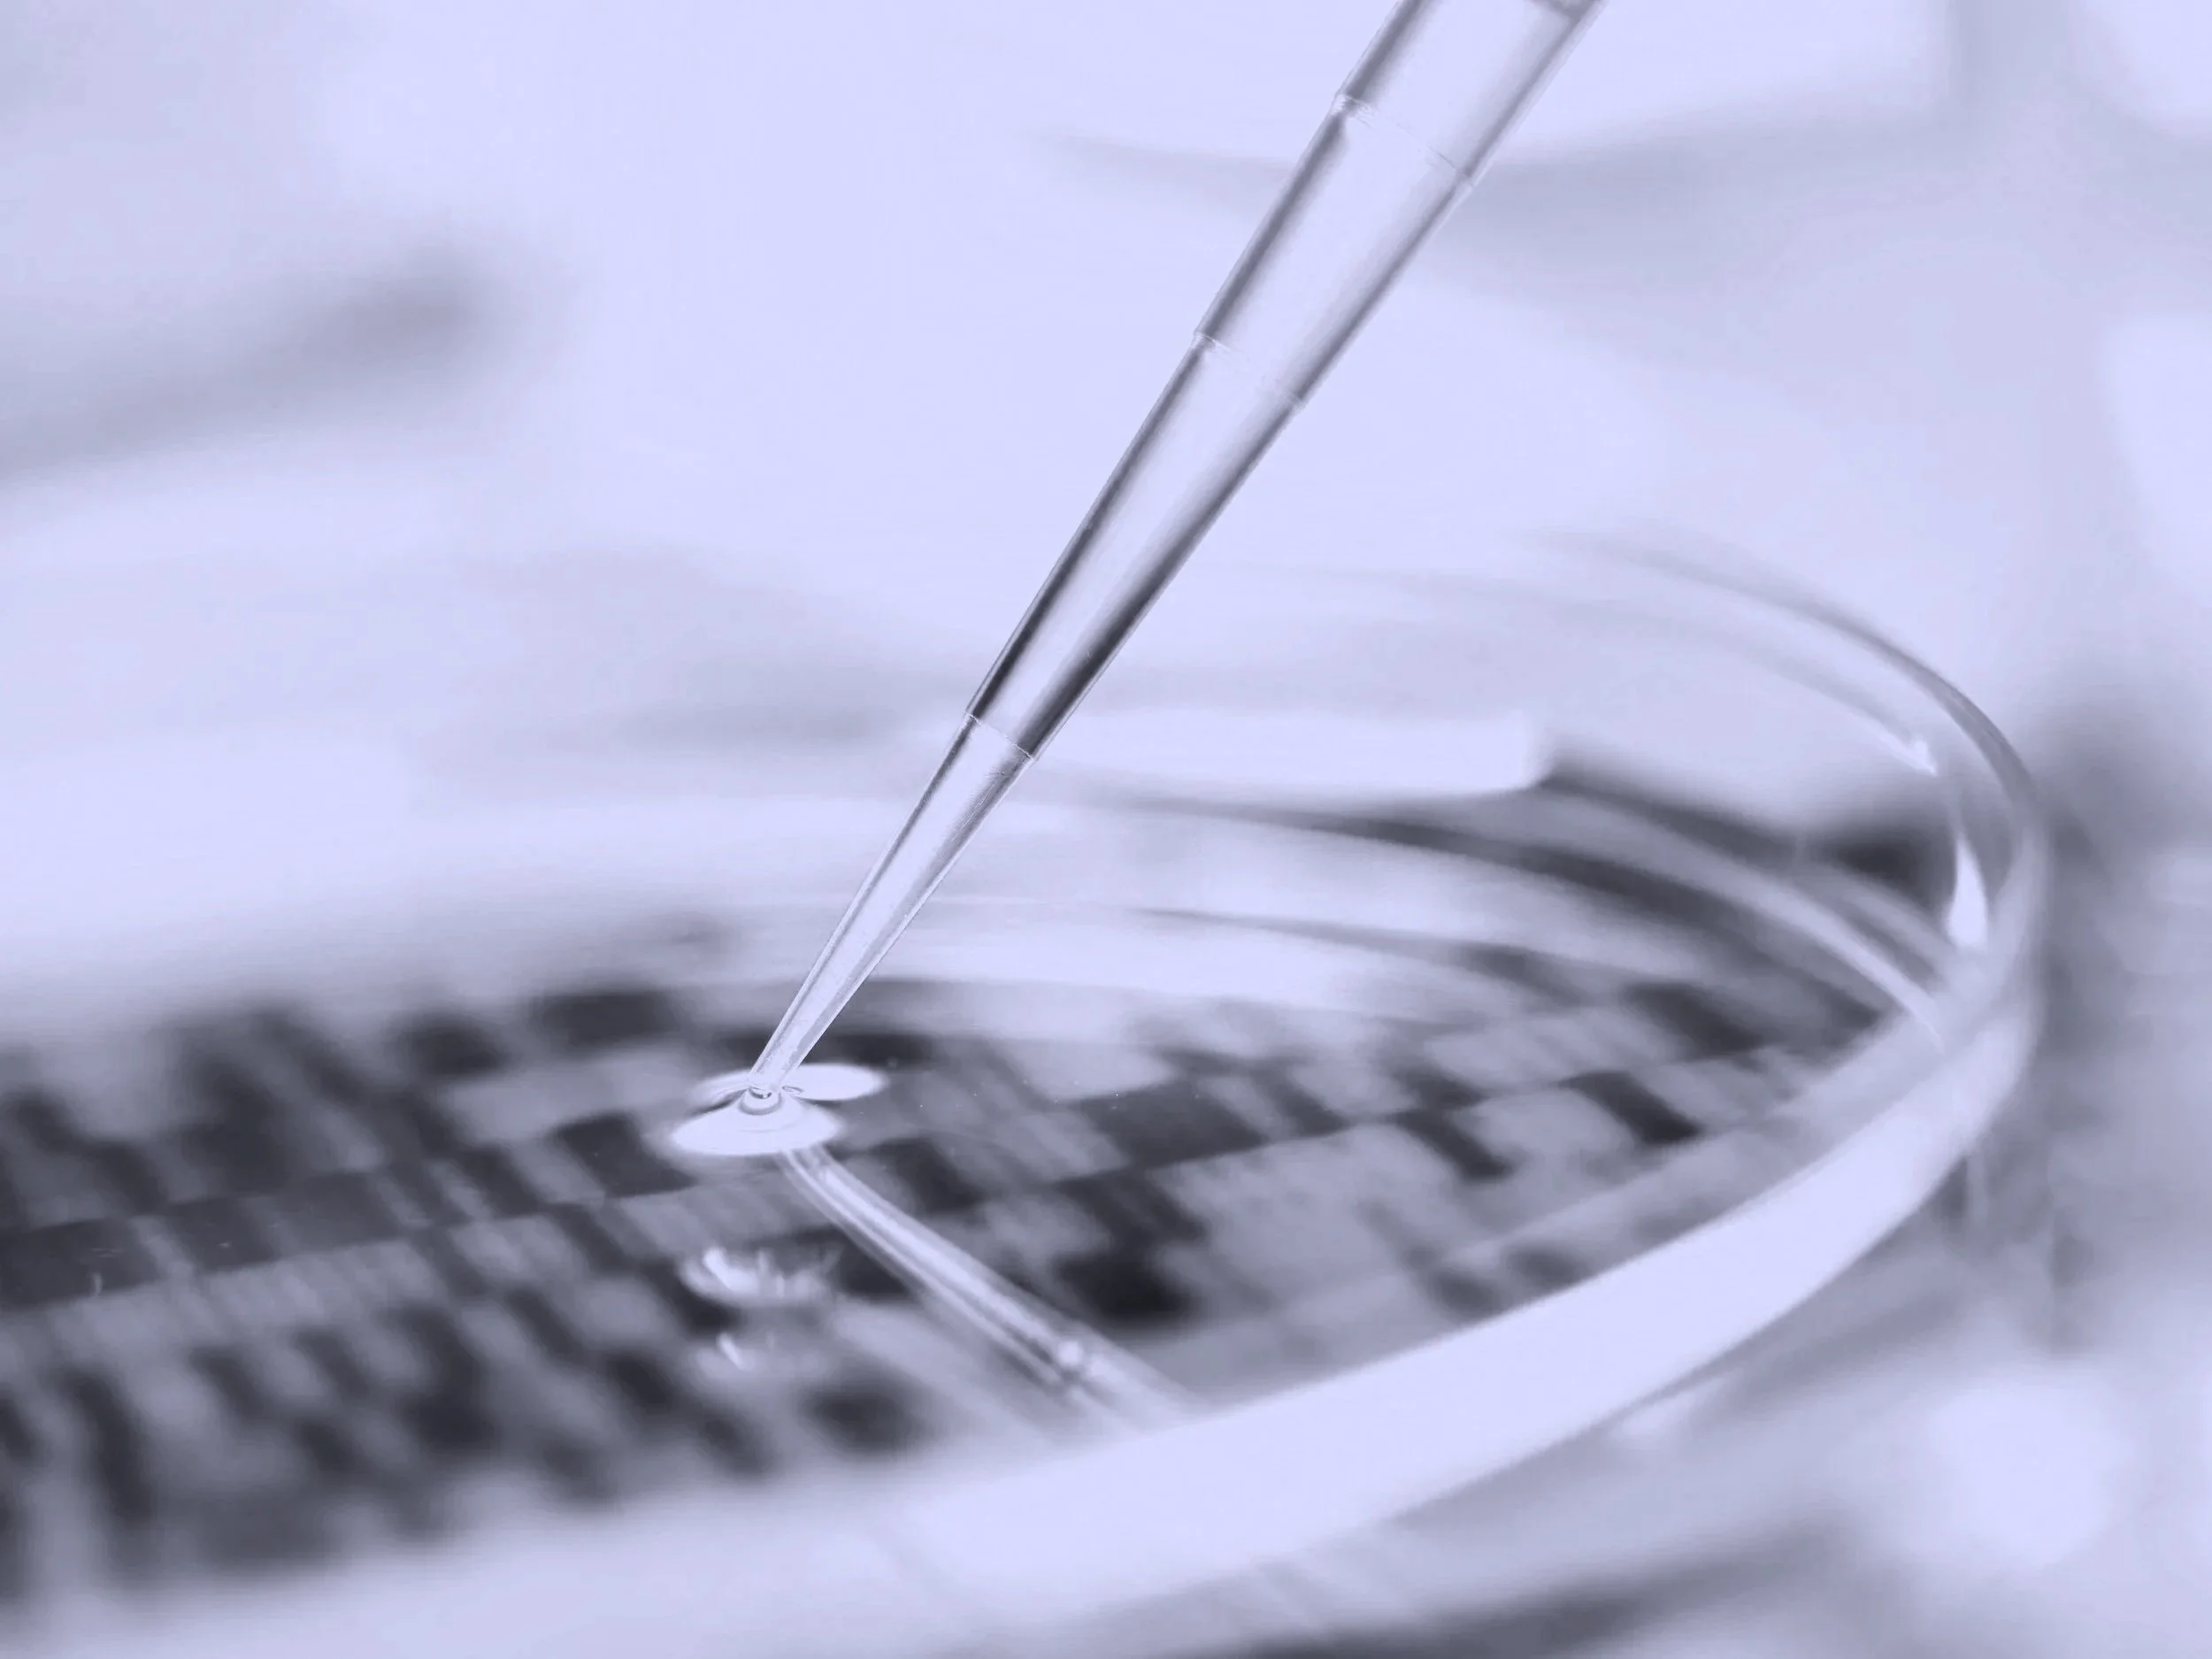

The InsiteXccelerator Pilot Track (IX) is an NIH grant within the I-RED Program for biomedical researchers committed to advancing their work through grant funding. This online training program is self-paced, ranging from two weeks to one month, and includes non-dilutive funding of up to $25,000 that is available to qualified candidates.
Also included is a dedicated mentor with expertise in the applicant's area of research. This grant is designed for biomedical researchers at all stages of their careers, independent of their interest in commercialization.